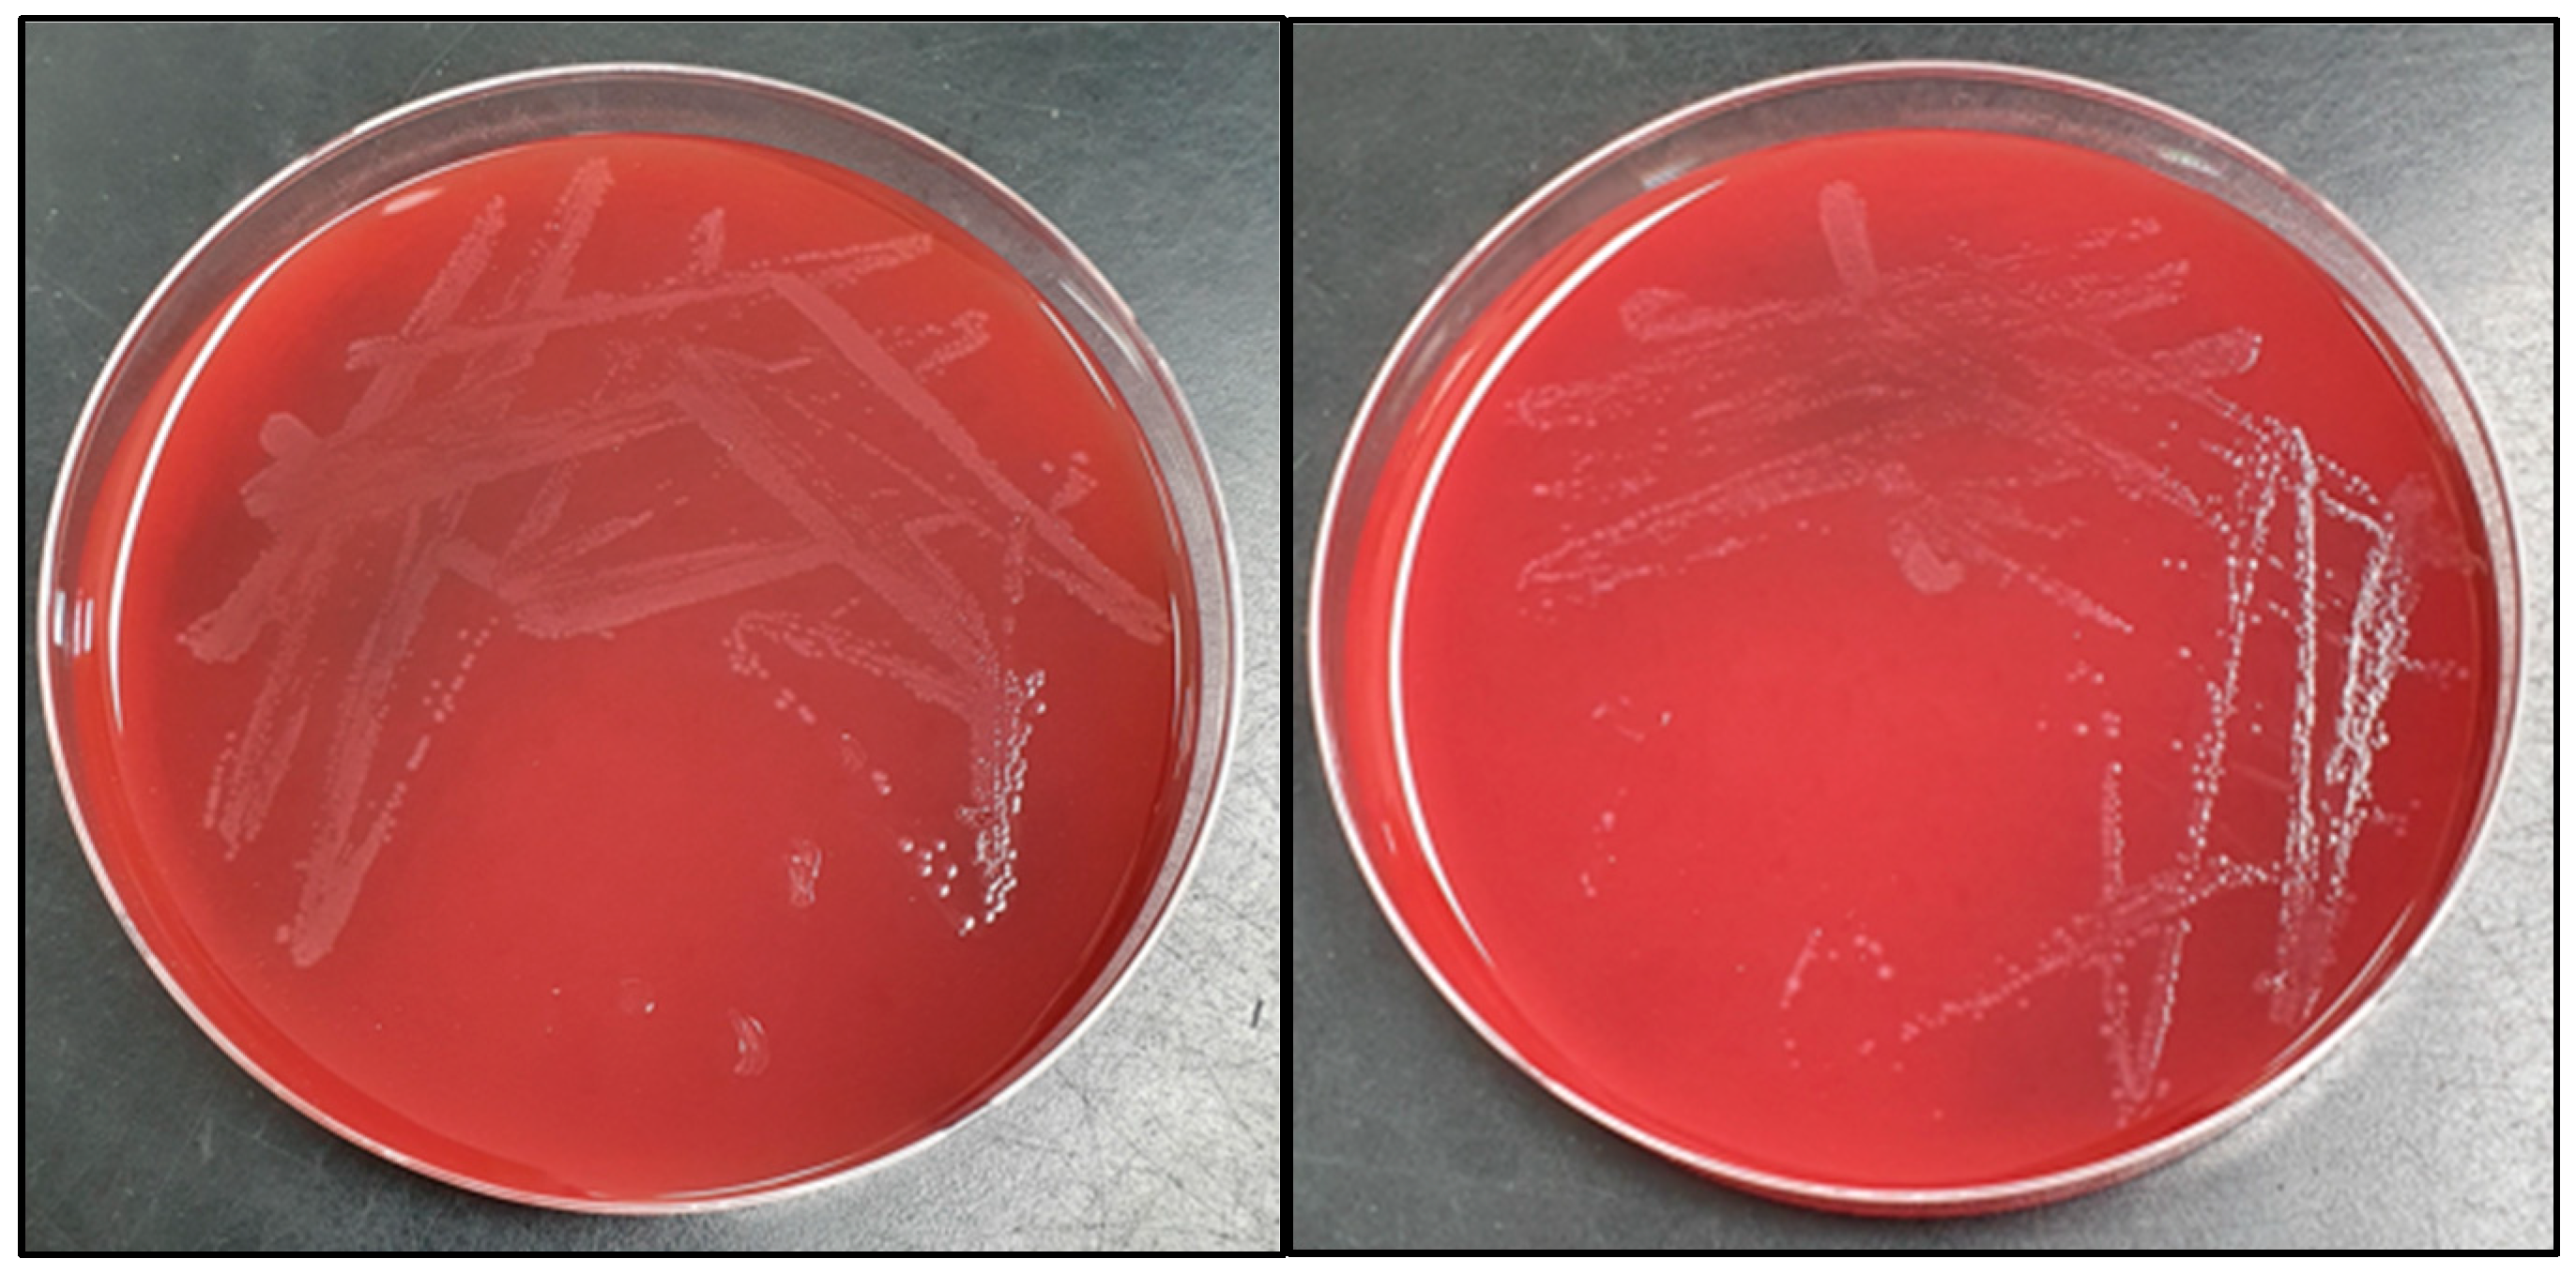
Children 09 01104 g002 Children 09 01104 g002

Digital Media Influence on Adolescents’ Behavior during the COVID-19 Pandemic: Self-Intravenous Injection of Lactobacilli Drinking Yogurt
Abstract
1. Introduction
2. Case Report
3. Discussion
Author Contributions
Funding
Institutional Review Board Statement
Informed Consent Statement
Data Availability Statement
Conflicts of Interest
References
- Marciano, L.; Ostroumova, M.; Schulz, P.J.; Camerini, A.-L.-L. Digital media use and adolescents’ mental health during the COVID-19 pandemic: A systematic review and meta-analysis. Front. Public Health 2022, 9, 793868. [Google Scholar] [CrossRef] [PubMed]
- Moreno, M.A.; Briner, L.R.; Williams, A.; Walker, L.; Christakis, D.A. Real use or “real cool”: Adolescents speak out about displayed alcohol references on social networking websites. J. Adolesc. Health 2009, 45, 420–422. [Google Scholar] [CrossRef] [PubMed]
- Dunlop, S.M.; More, E.; Romer, D. Where do youth learn about suicides on the internet, and what influence does this have on suicidal ideation? J. Child Psychol. Psychiatry 2011, 52, 1073–1080. [Google Scholar] [CrossRef] [PubMed]
- Blakemore, S.-J.; Mills, K.L. Is adolescence a sensitive period for sociocultural processing. Annu. Rev. Psychol. 2014, 65, 187–207. [Google Scholar] [CrossRef]
- Gardner, M.; Steinberg, L. Peer influence on risk taking, risk preference, and risky decision making in adolescence and adulthood: An experimental study. Dev. Psychol. 2005, 41, 625. [Google Scholar] [CrossRef] [PubMed]
- Gerwin, R.L.; Kaliebe, K.; Daigle, M. The interplay between digital media use and development. Child Adolesc. Psychiatr. Clin. 2018, 27, 345–355. [Google Scholar] [CrossRef]
- Moreno, M.A.; Ton, A.; Selkie, E.; Evans, Y. Secret society 123: Understanding the language of self-harm on instagram. J. Adolesc. Health 2016, 58, 78–84. [Google Scholar] [CrossRef]
- Jacob, N.; Evans, R.; Scourfield, J. The influence of online images on self-harm: A qualitative study of young people aged 16–24. J. Adolesc. 2017, 60, 140–147. [Google Scholar] [CrossRef]
- Van Hoorn, J.; Crone, E.A.; Van Leijenhorst, L. Hanging out with the right crowd: Peer influence on risk-taking behavior in adolescence. J. Res. Adolesc. 2017, 27, 189–200. [Google Scholar] [CrossRef]
- Fournier, A.K.; Hall, E.; Ricke, P.; Storey, B. Alcohol and the social network: Online social networking sites and college students’ perceived drinking norms. Psychol. Pop. Media Cult. 2013, 2, 86. [Google Scholar] [CrossRef]
- Chein, J.; Albert, D.; O’Brien, L.; Uckert, K.; Steinberg, L. Peers Increase Adolescent Risk Taking by Enhancing Activity in the Brain’s Reward Circuitry; Wiley Online Library: Hoboken, NJ, USA, 2011. [Google Scholar]
- Albert, D.; Steinberg, L. Peer influences on adolescent risk behavior. In Inhibitory Control and Drug Abuse Prevention; Springer: Berlin/Heidelberg, Germany, 2011; pp. 211–226. [Google Scholar]
- Isenberg, H. Indigenous and pathogenic microorganizms of humans. In Manual of Clinical Microbiology; American Society for Microbiology: Washington, DC, USA, 1995; pp. 5–18. [Google Scholar]
- Husni, R.N.; Gordon, S.M.; Washington, J.A.; Longworth, D.L. Lactobacillus bacteremia and endocarditis: Review of 45 cases. Clin. Infect. Dis. 1997, 25, 1048–1055. [Google Scholar] [CrossRef] [PubMed]
- Antony, S.J.; Stratton, C.W.; Dummer, J.S. Lactobacillus bacteremia: Description of the clinical course in adult patients without endocarditis. Clin. Infect. Dis. 1996, 23, 773–778. [Google Scholar] [CrossRef] [PubMed]
- Pasala, S.; Singer, L.; Arshad, T.; Roach, K. Lactobacillus endocarditis in a healthy patient with probiotic use. IDCases 2020, 22, e00915. [Google Scholar] [CrossRef]
- Danielsen, M.; Wind, A.; Leisner, J.; Arpi, M. Antimicrobial susceptibility of human blood culture isolates of lactobacillus spp. Eur. J. Clin. Microbiol. Infect. Dis. 2007, 26, 287–289. [Google Scholar] [CrossRef]
- Griffiths, J.K.; Daly, J.S.; Dodge, R.A. Two cases of endocarditis due to lactobacillus species: Antimicrobial susceptibility, review, and discussion of therapy. Clin. Infect. Dis. 1992, 15, 250–255. [Google Scholar] [CrossRef] [PubMed]
- Baker, T.; Pelfrey, W.V., Jr. Bullying victimization, social network usage, and delinquent coping in a sample of urban youth: Examining the predictions of general strain theory. Violence Vict. 2016, 31, 1021–1043. [Google Scholar] [CrossRef] [PubMed]
- Vannucci, A.; Simpson, E.G.; Gagnon, S.; Ohannessian, C.M. Social media use and risky behaviors in adolescents: A meta-analysis. J. Adolesc. 2020, 79, 258–274. [Google Scholar] [CrossRef]
- Ahern, N.R.; Sauer, P.; Thacker, P. Risky behaviors and social networking sites: How is youtube influencing our youth? J. Psychosoc. Nurs. Ment. Health Serv. 2015, 53, 25–29. [Google Scholar] [CrossRef]
- Branley, D.B.; Covey, J. Is exposure to online content depicting risky behavior related to viewers’ own risky behavior offline? Comput. Hum. Behav. 2017, 75, 283–287. [Google Scholar] [CrossRef]
- Garner, J.; O’Sullivan, H. Facebook and the professional behaviours of undergraduate medical students. Clin. Teach. 2010, 7, 112–115. [Google Scholar] [CrossRef]
- O’Keeffe, G.S.; Clarke-Pearson, K.; Council on Communications and Media. The impact of social media on children, adolescents, and families. Pediatrics 2011, 127, 800–804. [Google Scholar] [CrossRef] [PubMed]
- Tsai, J.Y.; Kelley, P.G.; Cranor, L.F.; Sadeh, N. Location-sharing technologies: Privacy risks and controls. Isjlp 2010, 6, 119. [Google Scholar]
- Vente, T.; Daley, M.; Killmeyer, E.; Grubb, L.K. Association of social media use and high-risk behaviors in adolescents: Cross-sectional study. JMIR Pediatrics Parent. 2020, 3, e18043. [Google Scholar] [CrossRef] [PubMed]
- Aziza, D.N.; Astuti, R.D. Evaluating the effect of youtube advertising towards young customers’ purchase intention. Presented at the 12th International Conference on Business and Management Research (ICBMR 2018), Bali, Indonesia, 7–8 November 2018; Atlantis Press: Amsterdam, The Netherlands, 2019; pp. 93–98. [Google Scholar]
- Linkletter, M.; Gordon, K.; Dooley, J. The choking game and youtube: A dangerous combination. Clin. Pediatrics 2010, 49, 274–279. [Google Scholar] [CrossRef]

Publisher’s Note: MDPI stays neutral with regard to jurisdictional claims in published maps and institutional affiliations. |
© 2022 by the authors. Licensee MDPI, Basel, Switzerland. This article is an open access article distributed under the terms and conditions of the Creative Commons Attribution (CC BY) license (https://creativecommons.org/licenses/by/4.0/).
Share and Cite
Koh, E.; Choi, I.; Choi, S.-A.; Kang, Y.-J.; Cho, H.-J. Digital Media Influence on Adolescents’ Behavior during the COVID-19 Pandemic: Self-Intravenous Injection of Lactobacilli Drinking Yogurt. Children 2022, 9, 1104. https://doi.org/10.3390/children9081104
Koh E, Choi I, Choi S-A, Kang Y-J, Cho H-J. Digital Media Influence on Adolescents’ Behavior during the COVID-19 Pandemic: Self-Intravenous Injection of Lactobacilli Drinking Yogurt. Children. 2022; 9(8):1104. https://doi.org/10.3390/children9081104
Chicago/Turabian StyleKoh, Eunjung, Insu Choi, Seul-A Choi, Yeo-Jin Kang, and Hwa-Jin Cho. 2022. "Digital Media Influence on Adolescents’ Behavior during the COVID-19 Pandemic: Self-Intravenous Injection of Lactobacilli Drinking Yogurt" Children 9, no. 8: 1104. https://doi.org/10.3390/children9081104
APA StyleKoh, E., Choi, I., Choi, S.-A., Kang, Y.-J., & Cho, H.-J. (2022). Digital Media Influence on Adolescents’ Behavior during the COVID-19 Pandemic: Self-Intravenous Injection of Lactobacilli Drinking Yogurt. Children, 9(8), 1104. https://doi.org/10.3390/children9081104

